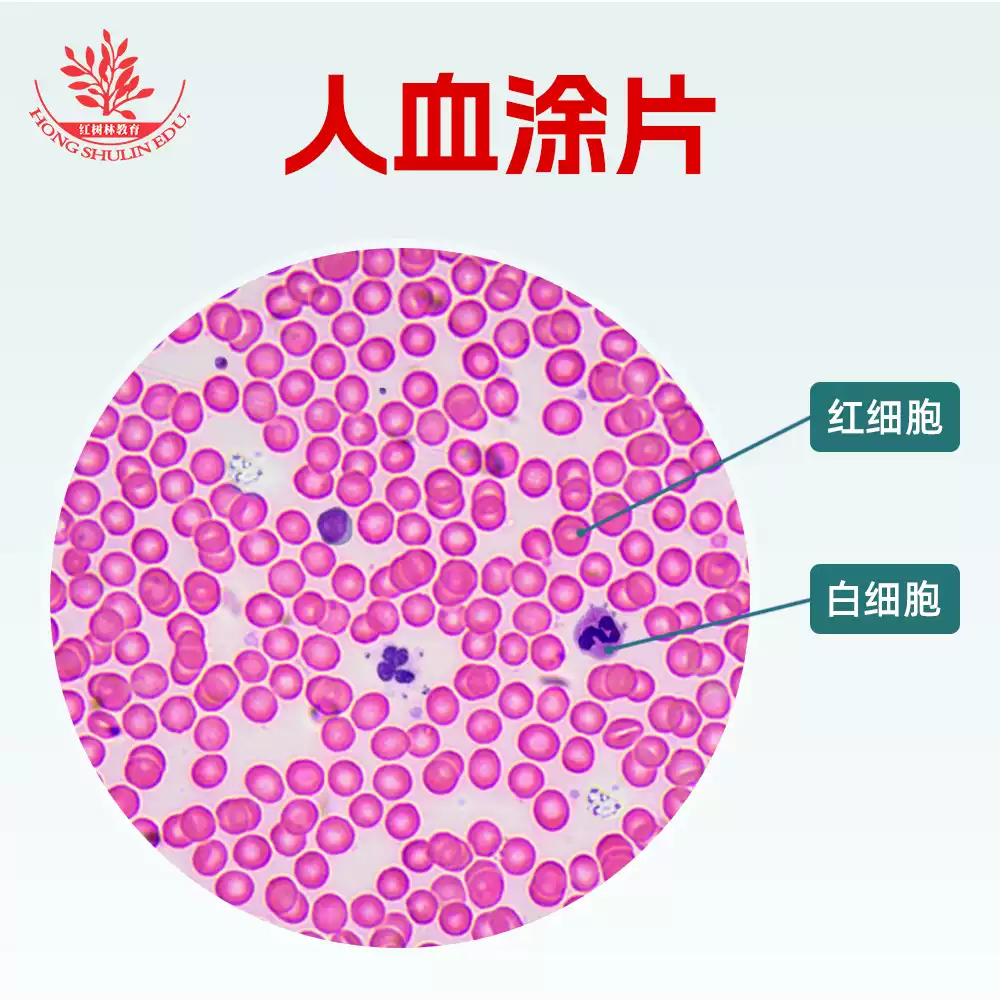
骨髄球 - Wikipedia, image size:1000x1000

Nwredhead
Gallery · January 24, 2025
白血球構造
白血球構造 PPT - 5-2 循環作用與養份運輸PowerPoint Presentation, free download - ID 4612925


単球・白血球の種類 ストックベクター ©edesignua 103465662
image size: 1024x1024

第3問の解説:白血球は大きく分けて、単球、リンパ球、顆粒球がある。これらは細胞の構造 で分類される。動物細胞は核膜により核と細胞質に分けられ、細胞膜で覆われておる。白血球は、細胞の大きさ、核の形や数、細胞質の性質で分類されるぞ。#免疫 #勉強垢 #免疫ふしぎ未来
image size: 1200x750

不同类型白血球的百分比。 白细胞分子式。 中性粒细胞,单核细胞,淋巴细胞,嗜酸性粒细胞,嗜碱性粒细胞。 细胞杀手。 免疫辅助细胞。 信息图形。 B.病媒. 图库矢量图©mikrostoker 312587208
image size: 1495x1700

免疫系统的步兵白血球细胞执行免疫系统防御任务的是一群勤劳的士兵, 也就是白血球细胞。它们主要包括下列几个种类: The body immune soldiers are the white blood cells. They consist primarily of B cells, T cells, phagocytes and granulocytes. Their functions are ...
image size: 1280x1708

🛜**人類白血球抗原** (The human leukocyte antigen (HLA)): \u200b 🔸捐贈者和腎友的HLA 標記之間的密切匹配,對於成功的移植結局至關重要。 \u200b 🔸研究發現,捐贈者必須至少匹配
image size: 1088x1220

hsieh-shie-liang-02 - PanSci 泛科學
image size: 2346x2217

基因檢驗-gene-2-chimera
image size: 1920x1600

造血干细胞的分化形成白细胞库存矢量图(免版税)216813523 | Shutterstock
image size: 1500x1101

第一節發炎第二節修復
image size: 1440x1104

202505癌症新知電子報
image size: 1600x1700

单核细胞的结构。单核细胞血细胞。白血球免疫白血病细胞。信息图形。孤立背景下的矢量说明. 图库矢量图©mikrostoker 356391794
image size: 1174x1600

描绘人类免疫细胞,包括巨噬细胞和肥大细胞的载体插图,展示了免疫系统的生物学和单核细胞的免疫学类型。 库存矢量图(免版税)2626094863 | Shutterstock
image size: 1536x1354

解開兒童癌症之謎:ALT 癌細胞如何逃避免疫系統? - PanSci 泛科學
image size: 1412x904

國家地理雜誌- 血液是由什麼構成的? 血液含有三種細胞:紅血球細胞、白血球細胞和血小板。 這些細胞漂浮在一種叫做血漿的淡黃色液體中。 血液當中有55%是血漿,44%是紅血球細胞,剩下的1%是白血球細胞與血小板。 | Facebook
image size: 963x1024

人类细胞的细胞核的结构。信息图表。对孤立背景矢量图图库矢量图©mikrostoker 135646024
image size: 2048x1152

民眾演講| PPTX
image size: 2048x1536

Ch11-1病原體| PPT
image size: 2000x1047

白血球の数と分類|マンボウ@血液内科医
image size: 2778x2214

hu-che-ming-03 - PanSci 泛科學
image size: 2048x1536

秒懂家醫科- 【門診醫學】高膽固醇血症的治療建議低密度脂蛋白過多是造成粥狀動脈硬化最重要的原因之一。 許多動脈的構造可以分成三層,其中內層與我們的心血管疾病很有關係。 血管內層上,面對血管管腔那一面鋪設了「血管內皮」。如果血管內皮受損,小小的低密度脂蛋白就 ...
image size: 1600x1588

细胞的免疫功能。设置。白细胞、 淋巴细胞、 嗜酸性粒细胞、 中性粒细胞、 单核细胞、 嗜碱性粒细胞、 树突状细胞。对孤立背景矢量图. 图库矢量图©mikrostoker 158066892
image size: 1000x1000
小兵立大功:淺談嗜中性白血球
image size: 2272x1704
骨髄球 - Wikipedia
image size: 1000x1000

瑞氏染色人血涂片生物实验用显微镜标本红白血球清晰显像
image size: 2778x3150

tao-mi-hua-06 - PanSci 泛科學
image size: 1024x768

PPT - 5-2 循環作用與養份運輸PowerPoint Presentation, free download - ID:4612925
image size: 1920x1440

白细胞数量折线图- 抖音
image size: 1600x1700

単球の構造。単球血細胞。マクロファージ。白血球の免疫。白血球よ。インフォグラフィックだ。孤立した背景のベクトル図. ストックベクター ©mikrostoker 357712622
image size: 2560x2560
認識身體的免疫篩檢站:脾臟- 臺大醫院雲林分院院訊
image size: 1548x1440

急性骨髓性白血病- 维基百科,自由的百科全书
image size: 1600x1666

血涂片中白血球对酵母细胞吞噬作用的研究真菌感染医学背景——图库图片© toeytoey #373135380
image size: 1500x975

Structure Leukocyte White Blood Cells Protection 库存插图2108220209 | Shutterstock
image size: 1000x1000

手術善其事- 你也有在大白天裡,看過飄在半空中的透明形體嗎? 別緊張~其實你看到的是👀 白血球+紅血球在視網膜中移動的軌跡唷! \u200b 我們視網膜中的微血管
image size: 1024x768

PPT - 兒童血液系統PowerPoint Presentation, free download - ID:3493238
image size: 4898x2978

Huang-Yen-Tsung-03-1 - PanSci 泛科學
image size: 1242x1660

白细胞数量折线图- 抖音
image size: 1200x1600

阿梅的生物圈一號~高中生物教學平台: 108高一生物細胞學說、構造與能量
image size: 1200x848

貓下泌尿道症候群(上篇)
image size: 1000x1000

CAR-T療法介紹(上):幫T淋巴球改造升級
image size: 2048x1866

The multifunctional immune system regulates physiology
image size: 4167x3808

hsueh-yen-ping-01 - PanSci 泛科學
image size: 2048x1536

Ch11-2非專一性反應| PPT
image size: 1100x917

白细胞介素-2 - Wikiwand
image size: 1500x1161

Diagram Showing Different Types White Blood 库存矢量图(免版税)1584019471 | Shutterstock
image size: 1556x739

白血球
image size: 1028x1028

免疫系統的好幫手!疫苗參上——《疫苗小小兵》 - PanSci 泛科學
image size: 1995x2800

白细胞、白血球| pluriSelect
image size: 768x1024

新大滿貫複習講義-生物(Page 48) - Flipbook by 翰林高中參考書| FlipHTML5
image size: 1024x768

組織學Vol 3 | PDF
image size: 2055x2800

PPT - 免疫系統之成員以及它們在防衛上之角色( Elements of the immune system and their roles in defense) PowerPoint Presentation - ID:6036638
image size: 1080x810

香吉試學測複習講義-生物(Page 78) - Flipbook by 翰林高中參考書| FlipHTML5
image size: 2048x1536

血管操作|血液_搜狐网
image size: 1600x900

Ch11-2非專一性反應| PPT
image size: 2000x1045

臭寶爸的育兒日誌: 出發吧!人體探險隊
image size: 1500x1000

任思颖葛美然
image size: 1417x1810

第二章:社區型肺炎| 台灣肺炎診治指引
image size: 1100x829

免疫≠ 不孕,我有免疫問題? — 王呈瑋醫師|生殖醫學科、婦產科
image size: 1500x1101

红血球简易画法- 抖音
image size: 1024x768

慢性淋巴细胞白血病- Wikiwand
image size: 768x1024

Neutrophil Vector Type White Blood Cell 库存矢量图(免版税)2334078819 | Shutterstock
image size: 1000x1000

PPT - 中性粒细胞: 免疫血液学- 先天性免疫PowerPoint Presentation - ID:6045213
image size: 1000x1396

第2章细胞结构和组织| PDF
image size: 3703x2420

Untitled
image size: 1280x720

中心法則與RNA藥物》下--RNA也能治病?
image size: 1132x1004

超圖解解剖學:完整了解身體構造與各器官功能
image size: 1440x1920

2-2 免疫不全宿主、特殊病原菌| 台灣肺炎診治指引
image size: 1305x870

環球生技月刊| 全球華人第一生醫產業KOL資料庫平台
image size: 1080x1043

多血症polycythemia與放血phlebotomy – 血液莓莓微物誌Belle's HemaScope
image size: 1600x1177

白细胞数量折线图- 抖音
image size: 1100x917

白血病的诊断与治疗
image size: 768x1024

阿梅的生物圈一號~高中生物教學平台: 108高一生物細胞學說、構造與能量
image size: 2120x1128

白细胞介素-8 - Wikiwand
image size: 3338x8334

02 - 選修生物I (全) 互動式教學講義- 第1章細胞的構造與功能(110f178851) | PDF
image size: 1500x1600

The No.5 of Wellness Health Club-How to take care of your eyes? by HC W - Issuu
image size: 1139x2160

2-2 免疫不全宿主、特殊病原菌| 台灣肺炎診治指引
image size: 2560x677

Neutrophil Type White Blood Cell Medical 库存矢量图(免版税)2126657123 | Shutterstock
image size: 2048x1536

以前在日本很喜歡去捐血的我發現,台灣和日本的捐血體重規定不太一樣😮 台灣: 女性應四十五公斤以上,男性應五十公斤以上。 捐分離術血小板、分離術白血球及分離術血漿者,應五十公斤以上。 日本: 400ml全血:男女應五十公斤以上。 200ml全血、分離術血小板、以及分離術 ...
image size: 1078x788

暸解組成人體的各種細胞種類- Ask The Scientists
image size: 2001x707

Ch11-1病原體| PPT
image size: 1377x1352

简笔画工作细胞红血球怎么画- 抖音
image size: 1500x957

潘新承獸醫師專欄】犬貓麻醉大哉問,飼主應該知道什麼?
image size: 768x1024
![白血球構造 實驗] 細胞醣類, image size:1920x1080](https://www.jove.com/files/media/science-education/science-education-thumbs/15402.jpg)
實驗] 細胞醣類
image size: 1920x1080

Types Giant Cells Eight Types Langhans 库存矢量图(免版税)2203369733 | Shutterstock
image size: 2000x1100

循環系統| PDF
image size: 1000x1000

赤血球生成に影響を与える要因
image size: 3000x1181

嬰幼兒保健食品怎麼挑選?小兒科許登欽醫師教您如何安心選擇
image size: 1258x1789

越野大賽:淺談人體中的細胞遷移(Cell migration)現象
image size: 1200x1600

三维组织工程化排列的星形胶质细胞网络, 以概括发展机制和促进神经系统再生
image size: 1800x1200

113南一國中生物教材簡介本by tinachennani - Issuu
image size: 1770x1047

阿梅的生物圈一號~高中生物教學平台: 108高一生物細胞學說、構造與能量
image size: 1140x1600

å °åŒ—æ¦®ç¸½å½±åƒ å¸æ¯ 月1例 - å °åŒ—æ¦®ç¸½æ•™å¸ç ”究部- å °åŒ—æ¦®æ°'總醫院
image size: 1024x768

白血病的诊断与治疗
image size: 1920x743

適康版國中良師-自然i學習(1) - 潘旅| 在线翻页PDF | FlipHTML5
image size: 1200x1200

Untitled
image size: 1859x1092

PPT - 5-2 循環作用與養份運輸PowerPoint Presentation, free download - ID:4612925
image size: 768x1024
Discover more galleries
- September 2025 Fortitudo Baseball Bologna Calendario Copa /2025-09/fortitudo-baseball-bologna-calendario-copa
- November 8, 2025 Wise Men Still Seek Him /2025-11-08/wise-men-still-seek-him
- September 2025 Fall Of Rome St Peters Chair /2025-09/fall-of-rome-st-peters-chair
- February 2025 Dannielynn Hope Marshall Birkhead /2025-02/dannielynn-hope-marshall-birkhead
- March 19, 2025 Jack Russell Teckel Mix Wit /2025-03-19/jack-russell-teckel-mix-wit
- October 21, 2025 Bordes De Flores Alrededor De Los Porches /2025-10-21/bordes-de-flores-alrededor-de-los-porches
- November 2025 Cara De Teñido De Hormigón Prefabricado /2025-11/cara-de-tenido-de-hormigon-prefabricado
- September 14, 2025 Book Stores In Melbourne Au /2025-09-14/book-stores-in-melbourne-au